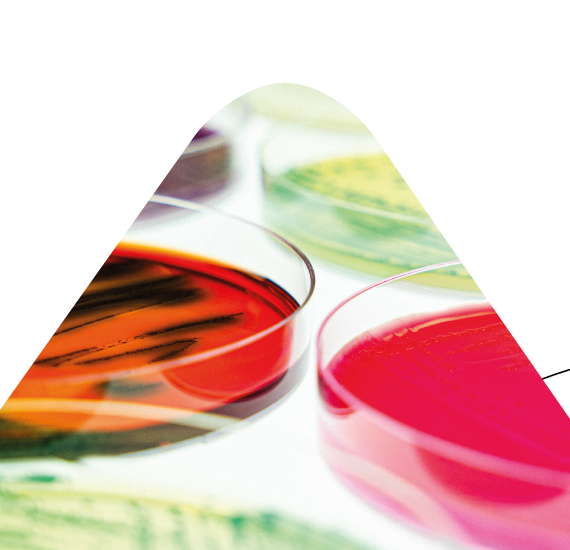

Comment valider la durée de vie microbiologique de vos produits en 2025 ? Ce webinaire apporte des réponses concrètes sur la réglementation DVM, les tests microbiologiques et les outils de validation.
Webinaire ADRIA x DGAL – 20 mai 2025
Plus de 330 professionnels de l’agroalimentaire se sont inscrits à ce webinaire pour faire le point sur la durée de vie microbiologique des aliments (DVM), enjeu crucial de sécurité sanitaire et de conformité réglementaire.
Pourquoi la DVM est-elle un sujet stratégique pour les industriels ?
Face aux attentes des autorités sanitaires, à l’évolution du règlement (CE) 2073/2005, aux exigences de traçabilité et à la gestion du risque microbiologique, la DVM représente un axe majeur de maîtrise qualité. Ce webinaire visait à clarifier les textes de référence et à proposer une application pratique des méthodes de validation, à travers trois études de cas concrètes.
Ce que vous allez apprendre dans ce replay
1. Comprendre le cadre réglementaire en 2025-2026
- Révision de l’instruction technique DVM (IT 2025-78)
- Mise à jour du critère Listeria monocytogenes applicable en juillet 2026
- Nouveautés du Codex Alimentarius
- Harmonisation des pratiques dans les GMS et projets européens en cours (guide LRUE)
2. Appliquer les méthodes de validation et de vérification DVM
- Tests de vieillissement alimentaire
- Tests de croissance microbiologique (potentiel et taux)
- Challenge test alimentaire (validation d’étapes de process)
- Utilisation de la microbiologie prévisionnelle (ex : Sym’Previus)
- Exemples concrets d’interprétation selon les normes ISO 20976 et NF V01-003
3. Cas pratiques présentés
- Tartinable et Listeria monocytogenes : potentiel de croissance à 0,2 log (produit ne permettant pas le développement)
- Salade traiteur : simulation du taux de croissance de Listeria monocytogenes selon les conditions réelles de stockage
- Jambon sans nitrite : Clostridium botulinum et évaluation via challenge test procédé
Visionner le replay
Ce webinaire est disponible en replay. Demander l’accès au replay en remplissant le formulaire.
Vous souhaitez valider la DVM de vos produits ?
Nos équipes vous accompagnent pour :
- Déterminer la durée de vie microbiologique selon vos produits et vos procédés
- Réaliser vos tests microbiologiques dans un laboratoire reconnu
- Vous aider à respecter la réglementation DVM à jour
- Former vos équipes en hygiène, traçabilité, DDM/DLC
📧 Contactez-nous pour un audit, un essai ou une formation.
FAQ – Durée de vie microbiologique des aliments
Comment valider la durée de vie microbiologique d’un aliment ?
→ En combinant une analyse des dangers, des tests de vieillissement ou de croissance, et l’interprétation des résultats selon les normes en vigueur (NF V01-003, ISO 20976).
Quelles sont les obligations réglementaires DVM en 2025 ?
→ Se référer à l’instruction IT 2025-78, au règlement (CE) 2073/2005, et aux révisions en cours sur les critères microbiologiques.
Quelle est la différence entre DLC et DDM ?
→ La DLC s’applique aux produits microbiologiquement très périssables, tandis que la DDM concerne les produits à conservation plus longue sans risque pour la santé.
Comment utiliser Sym’Previus pour la DVM ?
→ C’est un outil de microbiologie prévisionnelle reconnu, permettant de modéliser la croissance microbienne dans différentes conditions de pH, Aw et température.
Peut-on mutualiser les études de DVM entre entreprises ?
→ Oui, sous conditions, notamment en ce qui concerne les procédés identiques et les matrices similaires.
Aller plus loin
🔎 Découvrez nos autres contenus sur :

14 Avr 2026
14 Avr 2026  12 Mar 2026
12 Mar 2026  05 Mar 2026
05 Mar 2026  23 Fév 2026
23 Fév 2026 